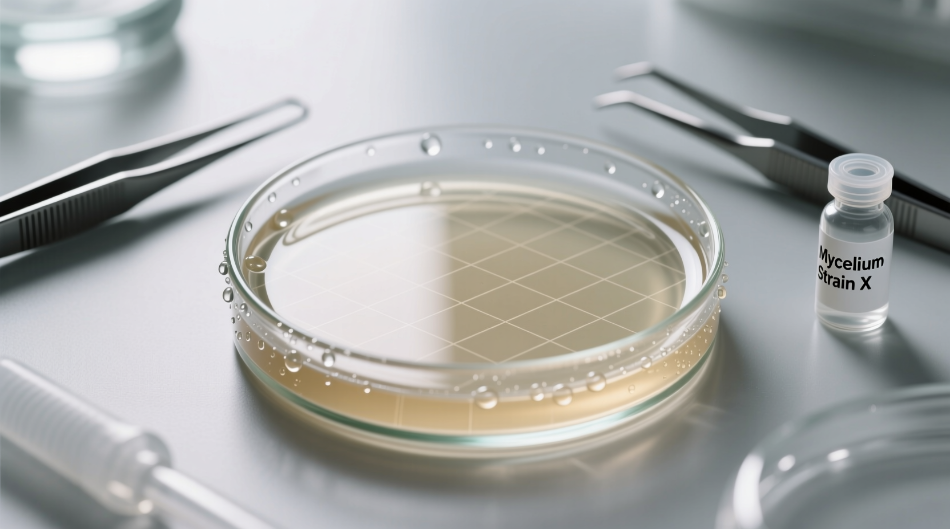
Agar-Agar zur Myzelvermehrung: Rezepte für fortgeschrittene Kulturmedien

Die Verwendung von Agar-Agar stellt eine der grundlegendsten und wesentlichsten Techniken in der modernen Mykologie dar und bietet Mykologen und Züchtern ein festes und steriles Medium zur Vermehrung und Untersuchung von Pilzmyzel. Dieser Artikel vertieft die fortschrittlichsten Methoden, um das Potenzial dieses außergewöhnlichen Polysaccharids voll auszuschöpfen, mit detaillierten Rezepten, Sterilisationsprotokollen und Inokulationstechniken, die Erfolg bei der Vermehrung der wertvollsten Pilzstämme garantieren. Durch diesen umfassenden Leitfaden werden wir jeden Aspekt der Zubereitung und Verwendung von Nährmedien auf Agar-Basis erkunden, wissenschaftliche Daten, detaillierte Statistiken und erprobte Verfahren zur Optimierung der Ergebnisse im professionellen und amateurhaften Pilzanbau liefern.
Agar-Agar hat die Mikrobiologie und Mykologie seit seiner Einführung im neunzehnten Jahrhundert revolutioniert und bietet eine elegante Lösung für das Problem der Kultivierung von Mikroorganismen auf festen Substraten. Abgeleitet aus Rotalgen der Gattungen Gelidium und Gracilaria, besitzt dieses natürliche Polymer einzigartige Eigenschaften, die es ideal für die Erstellung von Nährmedien machen: Es ist metabolisch inert, resistent gegen Abbau durch die meisten Mikroorganismen und bildet ein stabiles Gel bei Temperaturen von 35°C bis 100°C. Der Übergang von Sol zu Gel erfolgt bei etwa 32-40°C, was den Zusatz temperaturempfindlicher Nährstoffe ohne Beeinträchtigung der Mediumstruktur ermöglicht. Das tiefgreifende Verständnis dieser physikalisch-chemischen Eigenschaften ist entscheidend, um das Potenzial von Agar in der Myzelvermehrung voll auszuschöpfen. Die Geschichte von Agar-Agar in der Mykologie beginnt Ende des 19. Jahrhunderts, als der deutsche Mikrobiologe Walther Hesse auf Anregung seiner Frau Fanny begann, es als Alternative zu tierischer Gelatine zu verwenden, die sich bei Inkubationstemperaturen verflüssigte. Diese zufällige aber geniale Entdeckung ermöglichte es Robert Koch, die ersten festen Nährmedien für Bakterien zu entwickeln und legte so den Grundstein für die moderne Mikrobiologie. Auf dem Gebiet der Mykologie wurde Agar schnell zum Standard für die Isolierung und Reinigung von Pilzstämmen und ersetzte nach und nach empirische Methoden, die auf natürlichen Substraten wie Getreide, Sägemehl oder Holz basierten. Die Standardisierung von Nährmedien auf Agar-Basis ermöglichte bedeutende Fortschritte in der Pilztaxonomie, der Untersuchung der Pilzphysiologie und der Entwicklung kontrollierter Anbautechniken. Agar-Agar ist ein komplexes Polymer, das hauptsächlich aus Agarose und Agaropektin besteht. Der Gelierungsmechanismus ist physikalischer und nicht chemischer Natur: Die Polymerketten bilden eine dreidimensionale Struktur, die Wassermoleküle durch Wasserstoffbrückenbindungen einschließt. Die typische Konzentration für mykologische Anwendungen variiert zwischen 1,5 % und 2 % Gewichtsanteil, was 15-20 Gramm pro Liter Medium entspricht. Bei dieser Konzentration weist das resultierende Gel eine feste, aber nicht übermäßig starre Konsistenz auf, die sowohl das Myzelwachstum als auch die Möglichkeit von Transfers ohne Beschädigung der Pilzstruktur ermöglicht. Die Gelierungstemperatur von Agar (ca. 32-40°C) liegt deutlich unter der Schmelztemperatur (ca. 85°C), was eine breite Hysteresezone schafft, die Laborverfahren erheblich erleichtert. Die Zubereitung von Nährmedien mit Agar-Agar erfordert Präzision und Aufmerksamkeit für Details, da die Zusammensetzung des Mediums direkt die Wachstumsgeschwindigkeit, die Myzelmorphologie und die Expression der genetischen Eigenschaften des Pilzes beeinflusst. Es gibt zahlreiche Rezepte, von den einfachsten bis zu den komplexesten Formulierungen, jede mit spezifischen Vorteilen und Anwendungen. In diesem Abschnitt werden wir die grundlegenden Rezepte und ihre Varianten erkunden, mit genauen Angaben zu Konzentrationen, pH-Werten und Zubereitungsprotokollen. Die Wahl des geeigneten Mediums hängt von der Pilzart, dem Zweck der Kultur (Isolierung, Konservierung, Inokulumproduktion) und den verfügbaren Umweltbedingungen ab. Das Malzextrakt-Agar-Medium (MEA) ist das am häufigsten verwendete Nährmedium in der Mykologie aufgrund seiner Vielseitigkeit und der hervorragenden Unterstützung des Wachstums einer Vielzahl von Pilzen. Die klassische Formulierung sieht 20 Gramm Gerstenmalzextrakt, 15-20 Gramm Agar-Agar und 1 Liter destilliertes Wasser vor. Der Malzextrakt liefert eine ausgewogene Quelle aus einfachen und komplexen Kohlenhydraten, Aminosäuren, Vitaminen und essentiellen Mineralien für die Myzelentwicklung. Der pH-Wert des fertigen Mediums liegt normalerweise zwischen 5,0 und 5,5, ideal für die meisten saprophytischen und mykorrhizalen Pilze. Die Standardisierung von MEA hat signifikante Vergleiche zwischen verschiedenen Stämmen und Arten ermöglicht und die Arbeit der Identifizierung und Klassifizierung erleichtert. Die Zubereitung von MEA erfordert Aufmerksamkeit für Sterilität und Präzision der Messungen. Beginnen Sie mit dem genauen Abwiegen von 20g Gerstenmalzextrakt und 15g Agar-Agar hoher Reinheit, vorzugsweise in feinem Pulver für bessere Löslichkeit. Diese Komponenten zu 1 Liter destilliertem Wasser in einem Becherglas oder Pyrex-Kolben geben, unter Rühren mit einem Magnetrührer bei mittlerer Hitze erwärmen. Zum leichten Sieden bringen und weiterrühren, bis die Komponenten vollständig gelöst sind (ca. 5-10 Minuten). Es ist entscheidend, heftiges Sieden zu vermeiden, um die Karamellisierung von Zuckern und den thermischen Abbau von Nährstoffen zu verhindern. Nach vollständiger Auflösung wird das Medium im Autoklaven bei 121°C für 15-20 Minuten sterilisiert, dann auf 45-50°C abgekühlt, bevor es in die sterilen Petrischalen gegossen wird. Das Kartoffel-Dextrose-Agar-Medium (PDA) wird besonders geschätzt für die Kultivierung von Pilzen, die komplexe Kohlenstoffquellen und ein articulierteres Nährstoffprofil im Vergleich zum einfachen MEA benötigen. Die traditionelle Zubereitung sieht das Auslaugen von 200g frischen, geschälten und gewürfelten Kartoffeln in 1 Liter destilliertes Wasser für 30-60 Minuten bei 60-70°C vor, gefolgt von Filtration und Zugabe von 20g Dextrose und 15g Agar-Agar. Die Kartoffeln liefern Stärke, Mineralien und Wachstumsfaktoren, die die Entwicklung eines besonders kräftigen und kompakten Myzels stimulieren. PDA ist besonders geeignet für Basidiomyzeten wie Pleurotus ostreatus, Lentinula edodes und Agaricus bisporus, die auf diesem Substrat ein schnelleres und strukturierteres Wachstum zeigen. Das PDA-Basismedium kann durch Zugabe spezifischer Supplemente erheblich verbessert werden, die seine Leistung für bestimmte Anwendungen erhöhen. Für holzbewohnende Pilze und besonders anspruchsvolle Arten wird die Zugabe von 2g/L Hefeextrakt empfohlen, der B-Vitamine und essentielle Aminosäuren liefert. Um die Sporulation widerspenstiger Stämme zu fördern, kann die Ergänzung mit 0,5g/L Thiaminhydrochlorid (Vitamin B1) entscheidend sein. Bei wiederkehrenden bakteriellen Kontaminationen erzeugt die Zugabe von 50mg/L Streptomycinsulfat oder 100mg/L Ampicillin ein selektives Medium, das das Bakterienwachstum hemmt, ohne das Pilzmyzel negativ zu beeinflussen. Für Pilze, die besonders saure pH-Werte benötigen, wie einige Aspergillus- und Penicillium-Arten, kann Tartratsäure zugesetzt werden, um den pH-Wert auf 3,5-4,0 zu bringen. Während Standardmedien wie MEA und PDA für ein breites Spektrum von Pilzen geeignet sind, erfordern bestimmte Arten oder spezifische Anwendungen spezialisierte Formulierungen, die den einzigartigen metabolischen Bedürfnissen jeder Gattung entsprechen. In diesem Abschnitt werden wir für spezifische Gattungen optimierte Medien erkunden, mit Zusammensetzungen, die das Wachstum maximieren, die Fruktifikation in vitro fördern oder besondere enzymatische Aktivitäten unterstützen. Die Personalisierung des Nährmediums stellt ein mächtiges Werkzeug dar, um den Ertrag zu optimieren, die Myzelmorphologie zu kontrollieren und spezifische metabolische Pathways von Interesse zu induzieren. Die Kultivierung reiner mykorrhizaler Pilze auf Agar stellt eine besondere Herausforderung dar, da diese Organismen eine metabolische Abhängigkeit von der Wirtspflanze entwickelt haben. Medien für mykorrhizale Pilze müssen komplexe Kohlenstoffquellen wie Stärke oder Cellulose anstelle von einfachen Zuckern enthalten, die das Wachstum hemmen oder abnorme Myzelformen induzieren können. Eine wirksame Formulierung sieht 10g Kartoffelstärke, 2g Kaliumdihydrogenphosphat, 1g Magnesiumsulfat, 0,5g Calciumchlorid, 15g Agar-Agar und 1L destilliertes Wasser vor. Der pH-Wert sollte auf 5,8-6,2 eingestellt werden, um die Bodenbedingungen zu simulieren. Die Zugabe kleiner Mengen an Huminstoffen (0,1-0,5g/L) kann die natürliche Wurzelumgebung weiter nachahmen. Um das Wachstum mykorrhizaler Pilze in Abwesenheit der Wirtspflanze zu stimulieren, kann das Medium mit Extrakten aus Wurzeln spezifischer Wirtspflanzen ergänzt werden. Das Verfahren umfasst das Sammeln junger Wurzeln der Wirtspflanze, deren Oberflächensterilisation mit 70%igem Ethanol und 0,5%igem Natriumhypochlorit, gefolgt von Homogenisierung in sterilem destilliertem Wasser und Filtration. Der Extrakt wird dem Nährmedium in Konzentrationen von 1% bis 5% vor der Sterilisation zugesetzt. Alternativ kann die Zugabe von Phytohormonen wie Auxinen (Indol-3-essigsäure 0,1-1mg/L) oder Cytokininen (Kinetin 0,01-0,1mg/L) die chemischen Signale der Wirtspflanze teilweise nachahmen. Diese Ansätze haben sich als signifikant wachstumsfördernd für Tuber melanosporum, Cantharellus cibarius und andere wirtschaftlich wichtige mykorrhizale Pilze erwiesen. Sterilität ist der kritische Faktor, der über Erfolg oder Misserfolg bei der Kultivierung auf Agar entscheidet. Selbst das perfekt formulierte Nährmedium wird nutzlos sein, wenn es durch konkurrierende Mikroorganismen kontaminiert ist. In diesem Abschnitt werden wir die effektivsten Sterilisationsprotokolle analysieren, von Standard- bis zu fortgeschrittenen Techniken, mit besonderem Augenmerk auf die Prävention von Kontaminationen und das Management von Notfällen. Das Verständnis der mikrobiologischen Prinzipien hinter der Sterilisation ermöglicht es, Protokolle an spezifische Bedürfnisse anzupassen und Probleme zu lösen, die sonst gesamte Kulturchargen gefährden könnten. Das Autoklavieren stellt die zuverlässigste Sterilisationsmethode für Nährmedien auf Agar-Basis dar. Das physikalische Prinzip basiert auf der Verwendung von überhitztem Dampf unter hohem Druck, der es ermöglicht, Temperaturen über 121°C zu erreichen, die für die Zerstörung aller vegetativen Formen und der resistentesten Sporen notwendig sind. Der Standardzyklus sieht eine Exposition bei 121°C für mindestens 15-20 Minuten bei einem Druck von 1 atm über dem atmosphärischen Druck vor. Es ist entscheidend zu bedenken, dass die effektive Sterilisationszeit erst beginnt, wenn das gesamte Material im Autoklaven die Zieltemperatur erreicht hat, was je nach Behältervolumen mehrere zusätzliche Minuten dauern kann. Für besonders sporenreiche Medien oder mit hohem Gehalt an organischem Material wird empfohlen, die Sterilisationszeit auf 25-30 Minuten zu verlängern. Die Wirksamkeit des Autoklavierens wird stark vom Volumen und der Geometrie der verwendeten Behälter beeinflusst. Für Standard-Petrischalen (90-100mm Durchmesser) wird empfohlen, nicht mehr als 25-30mL Medium pro Schale zu verwenden, während für Laborflaschen das optimale Volumen 200-250mL für 500mL-Flaschen oder 400-450mL für 1000mL-Flaschen beträgt. Diese Volumen-/Oberflächen-Verhältnisse gewährleisten einen effizienten Wärmetransfer während der Sterilisation und eine angemessene Sauerstoffversorgung während des Myzelwachstums. Behälter mit flachen Böden und geraden Wänden ermöglichen eine homogenere Wärmeverteilung im Vergleich zu solchen mit gewölbten Böden oder unregelmäßigen Formen. Es ist wichtig, die Verschlüsse während des Autoklavierens leicht gelockert zu lassen, um die Gasausdehnung zu ermöglichen und ein Implodieren der Behälter während des Abkühlens zu verhindern. Die Inokulation von Nährmedien stellt die heikelste Phase des gesamten Prozesses dar, bei der das Myzel unter Bedingungen absoluter Sterilität übertragen wird. Die Inokulationstechniken beeinflussen nicht nur die Kolonisationsgeschwindigkeit, sondern auch die Vitalität des Stammes und die genetische Reinheit der Kultur. In diesem Abschnitt werden wir Standard- und fortgeschrittene Inokulationsmethoden erkunden, mit besonderem Augenmerk auf die Minimierung des Kontaminationsrisikos und die Optimierung der Myzelentwicklung. Die Beherrschung dieser Techniken ist entscheidend, um reine Stämme zu erhalten, die Degeneration von Kulturen zu verhindern und reproduzierbare Ergebnisse über die Zeit zu gewährleisten. Der Transfer von Mutterkulturen auf neue Agarschalen stellt die häufigste Operation in der Myzelvermehrung dar. Die korrekte aseptische Technik beinhaltet die Verwendung einer zuvor in der Flamme sterilisierten Impföse, die nach dem Abkühlen verwendet wird, um ein Fragment Myzel von der Mutterkolonie zu entnehmen. Die Entnahme sollte aus der Zone aktiven Wachstums erfolgen, typischerweise 1-2 cm vom Rand der Kolonie entfernt, wo das Myzel jung, vital und genetisch stabil ist. Das Fragment, mit einer Größe zwischen 2x2 mm und 5x5 mm, wird dann in der Mitte der neuen Schale abgelegt und leicht angedrückt, um einen guten Kontakt mit der Agaroberfläche zu gewährleisten. Für besonders langsam wachsende Arten ist es möglich, mehrere Punkte auf derselben Schale zu inokulieren, um die Kolonisationszeiten zu verkürzen. Die Wahl des für den Transfer zu entnehmenden Gewebes beeinflusst signifikant die Eigenschaften der neuen Kultur. Das Myzel unmittelbar hinter der Wachstumsfront weist die höchste metabolische Aktivität und genetische Stabilität auf, während zentralere, ältere Zonen Anzeichen von Seneszenz oder Mutationen zeigen können. Für Arten, die Rizomorphen bilden, sollte die Entnahme mindestens ein komplettes Rizomorphensegment umfassen, da diese spezialisierten Strukturen genetisch komplementäre Kerne enthalten, die für ein kräftiges Wachstum notwendig sind. Bei Pilzen, die Schnallenverbindungen (Clamp Connections) produzieren, ist es nützlich, vor dem Transfer das Vorhandensein dieser Strukturen mikroskopisch zu überprüfen, als Indikator für ein gesundes, dikaryotisches und genetisch stabiles Myzel. Die regelmäßige mikroskopische Überprüfung der Mutterkulturen ist entscheidend, um frühzeitig Anzeichen von Degeneration oder Kontamination zu identifizieren. Das Myzelwachstum auf Agar hängt nicht nur von der Zusammensetzung des Nährmediums ab, sondern auch von einer Reihe von Umweltparametern, die sorgfältig kontrolliert werden müssen, um die Ergebnisse zu maximieren. Temperatur, Luftfeuchtigkeit, Beleuchtung und Belüftung interagieren auf komplexe Weise und beeinflussen die Wachstumsgeschwindigkeit, die Myzelmorphologie und die Expression spezifischer Merkmale. In diesem Abschnitt werden wir die Wirkung jedes Parameters im Detail analysieren und Richtlinien für die Optimierung der Kulturbedingungen basierend auf den Pilzarten und spezifischen Zielen liefern. Die Temperatur ist einer der kritischsten Faktoren für das Myzelwachstum auf Agar. Jede Pilzart besitzt einen optimalen Temperaturbereich, der erheblich variieren kann, von 4-10°C für psychrophile Pilze wie Hericium erinaceus bis zu 35-40°C für thermophile wie Aspergillus fumigatus. Die meisten kultivierten Pilze wachsen optimal zwischen 20 und 28°C. Es ist wichtig zu beachten, dass die optimale Temperatur für das vegetative Wachstum sich signifikant von der für die Fruktifikation benötigten unterscheiden kann. Für gemäßigte Arten kann die Anwendung von Thermoperioden (zyklische Temperaturschwankungen) ein kräftigeres Wachstum stimulieren und die Bildung von Reproduktionsstrukturen induzieren. Die präzise Temperaturkontrolle ermöglicht die Synchronisation von Kulturen und die Optimierung von Produktionszeiten. Die relative Luftfeuchtigkeit in der Inkubationsumgebung beeinflusst direkt die Verdunstungsrate vom Agar, was wiederum die Nährstoffkonzentration und die Myzelmorphologie beeinflusst. Eine zu niedrige relative Luftfeuchtigkeit (unter 60%) verursacht übermäßige Verdunstung, was zu einer Konzentration des Mediums und möglicher Wachstumshemmung führt. Im Gegensatz dazu begünstigt eine zu hohe Luftfeuchtigkeit (über 90%) Kondensation an den Schalenwänden, erhöht das Kontaminationsrisiko und schafft mikroanaerobe Umgebungen. Die optimale Luftfeuchtigkeit für die meisten Agar-Kulturen liegt zwischen 75% und 85%. Um konstante Bedingungen aufrechtzuerhalten, können Inkubatoren mit Feuchtigkeitskontrolle oder einfachere Systeme wie geschlossene Behälter mit gesättigten Salzlösungen verwendet werden, die die relative Luftfeuchtigkeit auf spezifische Werte stabilisieren. Trotz Vorsichtsmaßnahmen können Agar-Kulturen auf verschiedene Probleme stoßen, die das Myzelwachstum beeinträchtigen oder die Entwicklung von Kontaminanten begünstigen. Die Fähigkeit, diese Probleme rechtzeitig zu identifizieren und korrekt einzugreifen, ist entscheidend für die Erhaltung gesunder und produktiver Kulturen. In diesem Abschnitt werden wir die häufigsten Probleme, ihre Ursachen und praktische Lösungen analysieren und auch präventive Strategien zur Minimierung des Ausfallrisikos bereitstellen. Der systematische Ansatz zur Problemlösung ermöglicht es, Misserfolge in Lern- und Verbesserungschancen zu verwandeln. Kontaminationen stellen das häufigste und frustrierendste Problem in Agar-Kulturen dar. Die korrekte Identifizierung des Kontaminanten ist der erste Schritt, um seine Herkunft zu bestimmen und ein Wiederauftreten zu verhindern. Bakterielle Kontaminationen manifestieren sich typischerweise als schleimige, glänzende Kolonien mit gleichmäßiger Farbe, während Schimmelpilze watteartige oder pulvrige Kolonien in verschiedenen Farben bilden. Hefen produzieren pastöse und cremige Kolonien. Kreuzkontaminationen von anderen Pilzkulturen können besonders tückisch sein, da der Kontaminant morphologisch ähnlich dem gewünschten Myzel sein könnte. Im Falle einer Kontamination ist es entscheidend, die betroffene Kultur sofort zu isolieren, die mögliche Quelle (Luft, Werkzeuge, Bediener, Medium) zu identifizieren und die Sterilisations- und aseptischen Arbeitsprotokolle zu überprüfen. Die Luftqualität in der Arbeitsumgebung ist ein kritischer Faktor zur Verhinderung von Kontaminationen. Laminarflow-Kabinen stellen den Goldstandard für aseptisches Arbeiten dar, indem sie einen konstanten Luftstrom bieten, der durch HEPA-Filter partikel- und mikoorganismenfrei gefiltert wird. Die Effizienz einer Laminarflow-Kabine hängt von der korrekten Wartung (regelmäßiger Filterwechsel, Dichtigkeitsprüfungen) und der sachgemäßen Verwendung (desinfizierte Arbeitsflächen, eingeschränkte Bewegungen während der Operationen) ab. In Abwesenheit einer Laminarflow-Kabine können Still Air Boxes (Ruhe-Luft-Boxen) verwendet werden, die, obwohl weniger effizient, das Kontaminationsrisiko signifikant reduzieren, indem sie eine semigeschützte Umgebung schaffen. Die regelmäßige Desinfektion der Arbeitsumgebung mit Natriumhypochlorit, Ethanol oder Wasserstoffperoxid ist essentiell, um akzeptable Sterilitätsstandards aufrechtzuerhalten. Die Langzeitkonservierung von Agar-Kulturen ist essentiell, um die Vitalität, genetische Stabilität und spezifischen Eigenschaften von Pilzstämmen zu erhalten. Verschiedene Methoden bieten unterschiedliche Kompromisse zwischen Dauer, Komplexität und Zuverlässigkeit. In diesem Abschnitt werden wir die effektivsten Techniken zur Konservierung von Kulturen erkunden, von einfachen Methoden für Hobbyisten bis zu kryogenen Protokollen für Referenzsammlungen. Die Wahl der geeigneten Methode hängt von den verfügbaren Ressourcen, der Häufigkeit der Kulturnutzung und der Bedeutung des konservierten genetischen Materials ab. Die Konservierung im Kühlschrank stellt die einfachste Methode zur mittelfristigen Konservierung von Agar-Kulturen dar. Frische, auf Petrischalen gewachsene Kulturen können bei 4°C für 3-6 Monate gelagert werden, abhängig von der Art und der Zusammensetzung des Mediums. Um die Haltbarkeit weiter zu verlängern, können verarmte Medien (mit geringerer Nährstoffkonzentration) verwendet werden, die den Metabolismus des Myzels verlangsamen. Im Kühlschrank konservierte Kulturen erfordern periodische Transfers auf frisches Medium, um die Vitalität aufrechtzuerhalten. Diese Methode birgt das Risiko der Akkumulation von Mutationen und genetischer Drift aufgrund wiederholten Subkultivierens, bleibt aber aufgrund ihrer Einfachheit und Zugänglichkeit weit verbreitet. Die Kryokonservierung in flüssigem Stickstoff (-196°C) stellt die effektivste Methode zur Langzeitkonservierung von Pilzkulturen dar. Bei diesen Temperaturen sind alle metabolischen und chemischen Prozesse praktisch ausgesetzt, was eine praktisch unbegrenzte Konservierung ohne genetische Veränderungen ermöglicht. Das Standardprotokoll sieht die Suspension von Myzelfragmenten oder Sporen in einer kryoprotektiven Lösung (üblicherweise 10% Glycerin oder 5% Dimethylsulfoxid) vor, gefolgt von einem kontrollierten Einfrieren (1°C/Minute) bis -80°C und anschließender Übertragung in flüssigen Stickstoff. Die Kryoprotektoren verhindern die Bildung intrazellulärer Eiskristalle, die Zellstrukturen schädigen würden. Diese Methode ist besonders geeignet für Referenzsammlungen, Mutantenstämme und wertvolles genetisches Material und gewährleistet Stabilität über Jahrzehnte. Die präzise Quantifizierung des Myzelwachstums auf Agar ist entscheidend, um die Wirksamkeit verschiedener Nährmedien, Umweltbedingungen oder experimenteller Behandlungen zu bewerten. Verschiedene Parameter können gemessen werden, von denen jeder spezifische Informationen über die Wachstumseigenschaften des Pilzes liefert. In diesem Abschnitt werden wir die gebräuchlichsten Methoden zur Messung des Wachstums erkunden, die geeigneten Techniken der statistischen Analyse und die Interpretation der Ergebnisse. Der quantitative Ansatz ermöglicht objektive Vergleiche zwischen Stämmen, systematische Optimierungen von Protokollen und ein tieferes Verständnis der Pilzphysiologie. Die Messung des Koloniedurchmessers stellt die einfachste und verbreitetste Methode zur Quantifizierung des Myzelwachstums auf Agar dar. Unter Verwendung eines Messschiebers oder eines Bildanalysesystems ist es möglich, die Zunahme des Koloniedurchmessers über die Zeit zu verfolgen, Wachstumskurven zu generieren, die analysiert werden können, um kinetische Parameter wie die Latenzzeit, die exponentielle Wachstumsrate und die stationäre Phase zu bestimmen. Für nicht perfekt kreisförmige Kolonien ist es üblich, zwei senkrechte Durchmesser zu messen und den Durchschnitt zu berechnen. Diese Methode ist besonders nützlich für schnelle Screenings und Vergleiche zwischen verschiedenen Stämmen oder Bedingungen, obwohl sie keine Informationen über die Dichte oder Biomasse des Myzels liefert. Die Techniken der computerisierten Bildanalyse bieten einen anspruchsvolleren Ansatz zur Charakterisierung des Myzelwachstums. Unter Verwendung spezialisierter Software wie ImageJ ist es möglich, nicht nur den Durchmesser, sondern auch die Fläche der Kolonie, die Myzeldichte und Texturparameter zu quantifizieren. Die Analyse von in regelmäßigen Abständen aufgenommenen Bildern ermöglicht den Aufbau von Wachstumskurven mit hoher zeitlicher Auflösung und die Identifizierung komplexer Wachstumsmuster. Fortgeschrittenere Techniken wie die Fourier-Analyse können die strukturelle Komplexität des Myzels charakterisieren, während die Farbanalyse Informationen über produzierte Metaboliten liefern kann. Diese Ansätze, obwohl komplexer, bieten eine umfassende Charakterisierung der Morphologie und Entwicklung der Kolonie. Die Techniken der Agar-Kultur beschränken sich nicht auf die einfache Vermehrung von Pilzen, sondern finden Anwendung in fortgeschrittenen Bereichen wie Gentechnik, selektiver Züchtung und Screening von Mutanten. In diesem Abschnitt werden wir erkunden, wie spezialisierte Nährmedien und Selektionstechniken auf Agar verwendet werden können, um Stämme mit verbesserten Eigenschaften zu entwickeln, die Pilzgenetik zu studieren und biotechnologische Anwendungen zu verfolgen. Diese Anwendungen repräsentieren die Grenze der angewandten Mykologie mit Implikationen für Landwirtschaft, Medizin und Industrie. Nährmedien auf Agar können so gestaltet werden, dass sie spezifische Mutanten oder Stämme mit gewünschten Eigenschaften selektieren. Die Zugabe von Antibiotika, Antimykotika oder metabolischen Inhibitoren schafft selektive Bedingungen, die nur das Wachstum resistenter Stämme erlauben. Analog kann das Weglassen spezifischer Nährstoffe (Minimalmedien) Stämme selektieren, die in der Lage sind, diese Verbindungen zu synthetisieren. Für das Screening von Stämmen mit verbesserter enzymatischer Aktivität können chromogene Substrate in das Medium eingebracht werden, die sichtbare Signale produzieren, wenn sie hydrolysiert werden. Diese Techniken werden weitgehend in Züchtungsprogrammen verwendet, um Stämme mit höherem Ertrag, Resistenz gegen Pathogene oder Fähigkeit zum Abbau komplexer Substrate zu entwickeln. Die Produktion und Regeneration von Protoplasten auf Agar stellt eine grundlegende Technik für die Gentechnik von Pilzen dar. Protoplasten sind von ihrer Zellwand durch enzymatische Behandlung befreite Pilzzellen, die so für externe DNA permeabel werden. Nach der Transformation mit dem gewünschten genetischen Konstrukt werden die Protoplasten auf Agar mit Osmoprotektoren (üblicherweise 0,6M MgSO4 oder Saccharose), die die osmotische Lyse verhindern, zur Regeneration gebracht. Regenerationsmedien sind typischerweise mit Nährstoffen angereichert, um die Wiederherstellung der Zellwand und die Wiederaufnahme der Zellteilung zu unterstützen. Die Transformanten werden dann auf Medien selektiert, die Antibiotika oder andere selektive Marker enthalten. Diese Technik hat die Entwicklung von Speisepilzstämmen mit verbesserten Eigenschaften ermöglicht, wie größerer Resistenz gegen Pathogene oder optimiertem Nährstoffgehalt. Die Verwendung von Agar-Agar in der Myzelvermehrung stellt eine ausgereifte, aber sich ständig weiterentwickelnde Technologie dar, mit neuen Anwendungen und Verbesserungen, die regelmäßig auftauchen. Von Grundformulierungen bis zu hochspezialisierten Medien, von einfachen Transfertechniken bis zu kryogenen Konservierungsprotokollen bleibt Agar das Fundament der praktischen Mykologie. Zukünftige Forschungsrichtungen umfassen die Entwicklung chemisch definierter Medien für präzise metabolische Studien, die Integration von Sensoren in Nährmedien für die Echtzeitüberwachung von Wachstumsparametern und die Optimierung nachhaltiger Formulierungen, die die Umweltauswirkungen reduzieren. Das tiefgreifende Verständnis der in diesem Artikel vorgestellten Prinzipien und Techniken bietet die Grundlage, um diese aufkommenden Grenzen zu erkunden und zum Fortschritt der mykologischen Wissenschaft beizutragen. Die Zukunft der Agar-Kultivierung erscheint vielversprechend, mit verschiedenen Forschungslinien, die die derzeitigen Praktiken revolutionieren könnten. Die Entwicklung alternativer Hydrogele mit verbesserten Eigenschaften (größere Transparenz, thermische Stabilität, regulierbare mechanische Eigenschaften) könnte einige Einschränkungen von traditionellem Agar überwinden. Die auf Pilzkulturen angewandte Mikrofluidik ermöglicht das Hochdurchsatz-Screening Tausender Bedingungen gleichzeitig und beschleunigt die Forschung erheblich. Die Integration von Omics-Techniken (Genomik, Transkriptomik, Proteomik, Metabolomik) mit Wachstumsstudien auf Agar verspricht, die komplexen metabolischen Netzwerke aufzudecken, die die Pilzentwicklung regulieren. Diese Fortschritte, kombiniert mit den hier beschriebenen traditionellen Techniken, eröffnen neue Möglichkeiten für das Verständnis und die Nutzung des Potenzials von Pilzen in Landwirtschaft, Medizin und Biotechnologie.Agar-Agar in der Mykologie: Geschichte und Grundprinzipien
Die historischen Ursprünge der Verwendung von Agar in der Mykologie
Der Gelierungsmechanismus: Eine detaillierte wissenschaftliche Erklärung
Konzentration (%) Gelkonsistenz Empfohlene Anwendungen Schmelztemperatur (°C) Gelierungstemperatur (°C) 1,0-1,2 Weich Kulturen wässriger Pilze, Beweglichkeitsstudien 82-85 32-35 1,5-1,8 Mittel (Standard) Allgemeine Kultur, Isolierung, Konservierung 85-88 34-38 2,0-2,5 Fest Langzeitkulturen, Stämme, die lytische Enzyme produzieren 88-92 36-40 3,0+ Sehr fest Spezielle Anwendungen, Resistenz gegen Austrocknung 92-95 38-42 Basisrezepte für Nährmedien mit Agar-Agar
Malzextrakt-Agar (MEA): Das Standardmedium schlechthin
Detaillierte Zubereitung von MEA: Schritt-für-Schritt-Anleitung
Malzextrakt-Konzentration (g/L) Wachstumsgeschwindigkeit Myzeldichte Bildung von Rizomorphen Empfohlene Anwendungen 10 Langsam Niedrig Selten Stammkonservierung, Sporulationsinduktion 20 Mittel Mittel Mäßig Allgemeine Verwendung, Vermehrung 30 Schnell Hoch Häufig Inokulumproduktion, langsame Stämme 40+ Sehr schnell Sehr hoch Reichlich Forschung, Biomasseproduktion PDA (Potato Dextrose Agar): Das nährstoffreiche Medium für anspruchsvolle Pilze
Fortgeschrittene Varianten von PDA: Anreicherungen und Modifikationen
Spezialisierte Nährmedien für spezifische Pilzgattungen
Medien für mykorrhizale Pilze: Die Wurzelsymbiose simulieren
Ergänzung mit Wurzelextrakten und Pflanzenhormonen
Pilzgattung Optimale Mediumzusammensetzung Idealer pH Wachstumstemperatur (°C) Kolonisationszeit (Tage) Agaricus MEA + 2g/L Hefeextrakt + 1g/L hydrolysierte Casein 7,0-7,5 24-26 10-14 Pleurotus PDA + 5g/L Reiskleie + 0,5g/L Mangansulfat 6,0-6,5 25-28 7-10 Lentinula MEA + 3g/L Holzextrakt + 1g/L Glycin 5,5-6,0 22-25 12-16 Tuber Stärke 10g/L + KH2PO4 1g/L + Eichenwurzelextrakte 3% 6,2-6,8 18-20 20-30 Fortgeschrittene Sterilisations- und Zubereitungsprotokolle
Autoklavieren: Physikalische Prinzipien und kritische Parameter
Management von Volumina und Behältergeometrien
Volumen pro Behälter (mL) Aufheizzeit (min) Sterilisationszeit bei 121°C (min) Abkühlzeit (min) Kontaminationsrisiko (%) 10-20 5-8 15 10-15 2-5 21-50 8-12 20 15-25 5-8 51-100 12-18 25 25-40 8-12 101-200 18-25 30 40-60 12-18
Fortgeschrittene Inokulationstechniken und Myzeltransfer
Transfer von Mutterkulturen: Grundlegende aseptische Techniken
Gewebeauswahl und genetische Stabilität
Optimierung der Umweltparameter für das Wachstum auf Agar
Temperaturkontrolle: Temperaturgradienten und Thermoperioden
Relative Luftfeuchtigkeit und Kontrolle der Verdunstung
Pilzart Optimale Temperatur (°C) Relative Luftfeuchtigkeit (%) Photoperiode (Stunden Licht/Dunkelheit) Optimales CO2 (ppm) Agaricus bisporus 24-26 80-85 0/24 2000-5000 Pleurotus ostreatus 25-28 75-80 12/12 1000-2000 Lentinula edodes 22-25 80-85 16/8 1000-1500 Ganoderma lucidum 26-30 85-90 12/12 1500-3000
Lösung häufiger Probleme in Agar-Kulturen
Identifikation und Management von Kontaminationen
Luftqualitätskontrolle und Laminarflow-Arbeitsplatz
Langzeitkonservierungstechniken für Agar-Kulturen
Konservierung im Kühlschrank: Techniken und Einschränkungen
Kryokonservierung in flüssigem Stickstoff: Der Goldstandard
Konservierungsmethode Geschätzte Dauer Vitalität nach Konservierung (%) Kosten für Ausrüstung Technische Komplexität Kühlschrank (4°C) 3-6 Monate 80-95 Niedrig Niedrig Mineralöl 1-2 Jahre 70-90 Niedrig Mittel Gefriertrocknung 5-10 Jahre 40-70 Mittel Hoch Kryokonservierung (-196°C) 10+ Jahre 80-95 Hoch Hoch
Statistische Analyse und Messung des Myzelwachstums
Messung des Koloniedurchmessers und kinetische Analyse
Bildanalyse und computerisierte Techniken
Fortgeschrittene Anwendungen: Gentechnik und Züchtung auf Agar
Selektion von Mutanten und Screening auf selektiven Medien
Protoplasten und genetische Transformation auf Agar
Agar-Agar: Unverzichtbar für professionelle Züchter
Forschungsperspektiven und zukünftige Entwicklungen